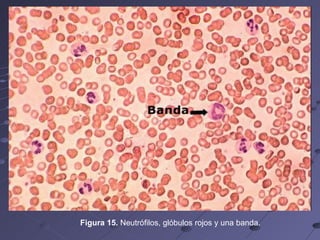
Figura 15.  Neutrófilos, glóbulos rojos y una banda.
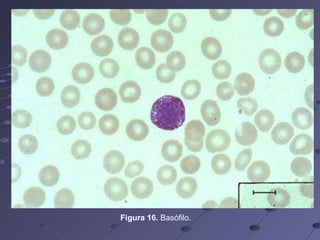
Figura 16.  Basófilo.
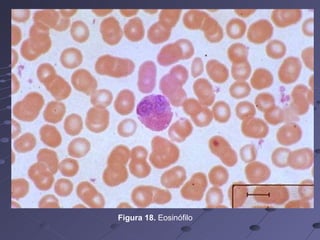
Figura 18.  Eosinófilo
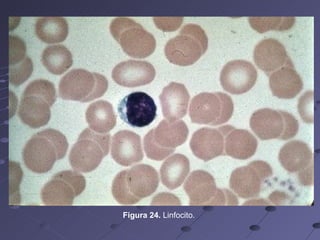
Figura 24.  Linfocito.
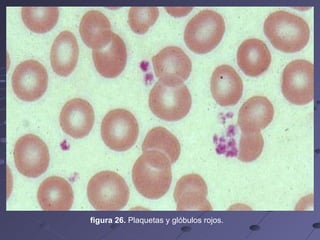
figura 26.  Plaquetas y glóbulos rojos.
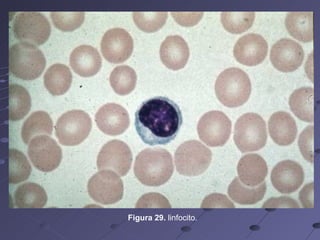
Figura 29.  linfocito.

La médula ósea es un tejido blando dentro de los huesos que forma las células sanguíneas a través de un proceso llamado hematopoyesis. Produce glóbulos rojos, glóbulos blancos y plaquetas a partir de células madre. Estas células sanguíneas transportan oxígeno, nutrientes y desechos por el cuerpo, y ayudan a defenderlo de infecciones.